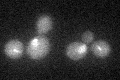
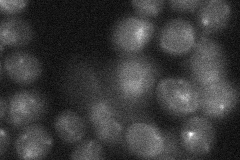

View description
Aurora kinase subunit of the conserved chromosomal passenger complex (CPC; Ipl1p-Sli15p-Bir1p-Nbl1p), involved in regulating kinetochore-microtubule attachments; helps maintain condensed chromosomes during anaphase and early telophase
Localization:
Intensity:
Fold change:
Significance:
-
C’ GFP library in SD
punctate19.96 -
N' NOP1pr-GFP in SD

punctate,nucleus38.1161 -
N' TEF2pr-mCherry in SD

cell periphery,vacuoleN/A -
N' NATIVEpr-GFP in SD
punctate22.9671 -
N' TEF2pr-VC and Cyto-VN in SD

#N/A0 -
C’ GFP library in SD+DTT

punctate19.70.98No -
C’ GFP library in SD+H2O2

punctate20.941.04No -
C’ GFP library in Starvation Media

punctate26.751.33No -
C’ GFP library on the background of Pup2-DaMP

punctate -
C’ GFP library on the background of CCT mutant

punctate18.76670.939607No
